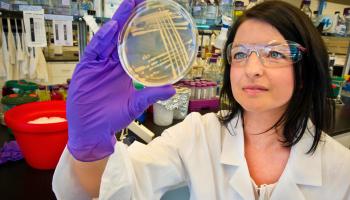
female scientist looking at a petri dish

ChemEd X contributors and staff members are continually coming across items of interest that they feel others may wish to know about. Picks include, but need not be limited to, books, magazines, journals, articles, apps—most anything that has a link to it can qualify.
Many Picks can be purchased from Amazon. Using the Amazon links on those pages help to support ChemEd X.
pick